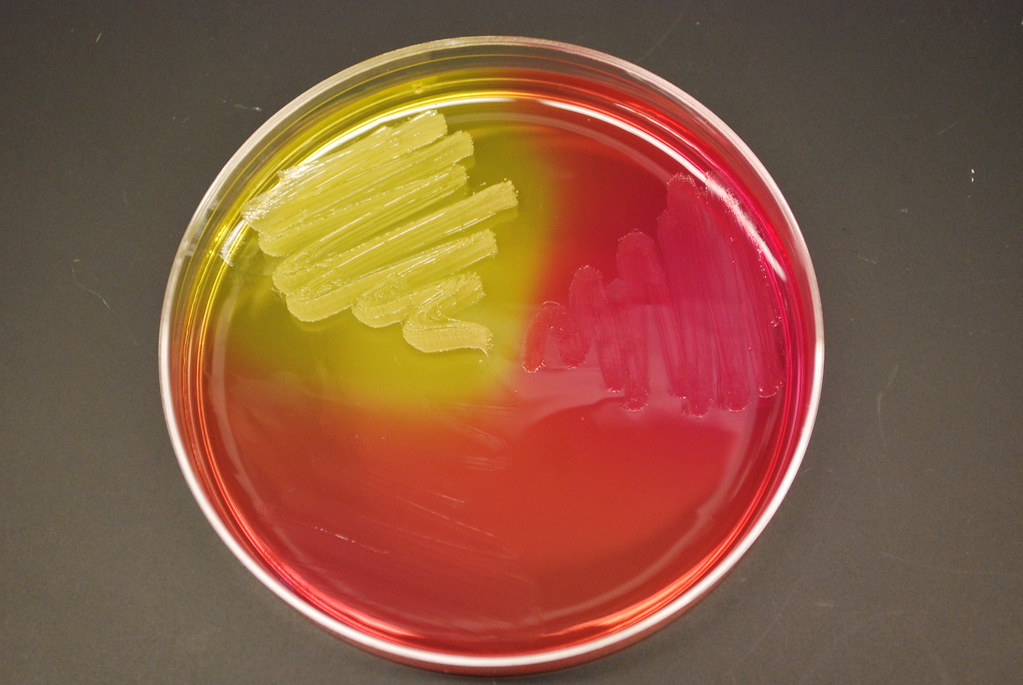
<p>In Mannitol Agar, what does the yellow media indicate?</p>
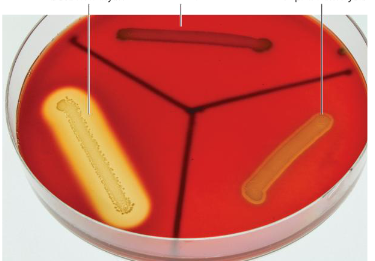
<p>What type of media is Blood agar? </p>
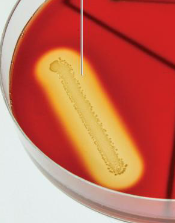
<p>What type of hemolysis is shown in the blood agar? </p>
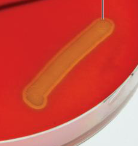
<p>What type of hemolysis is shown in the blood agar? </p>
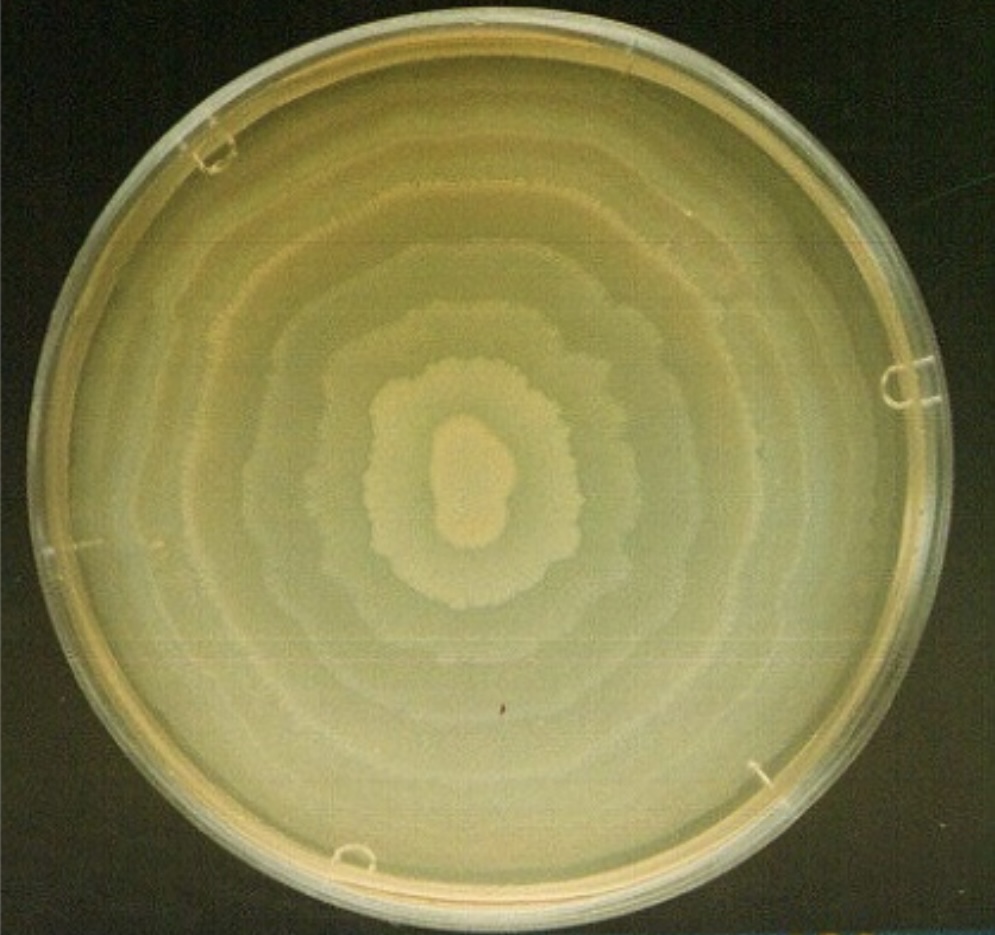
<p>What does this plate show? </p>
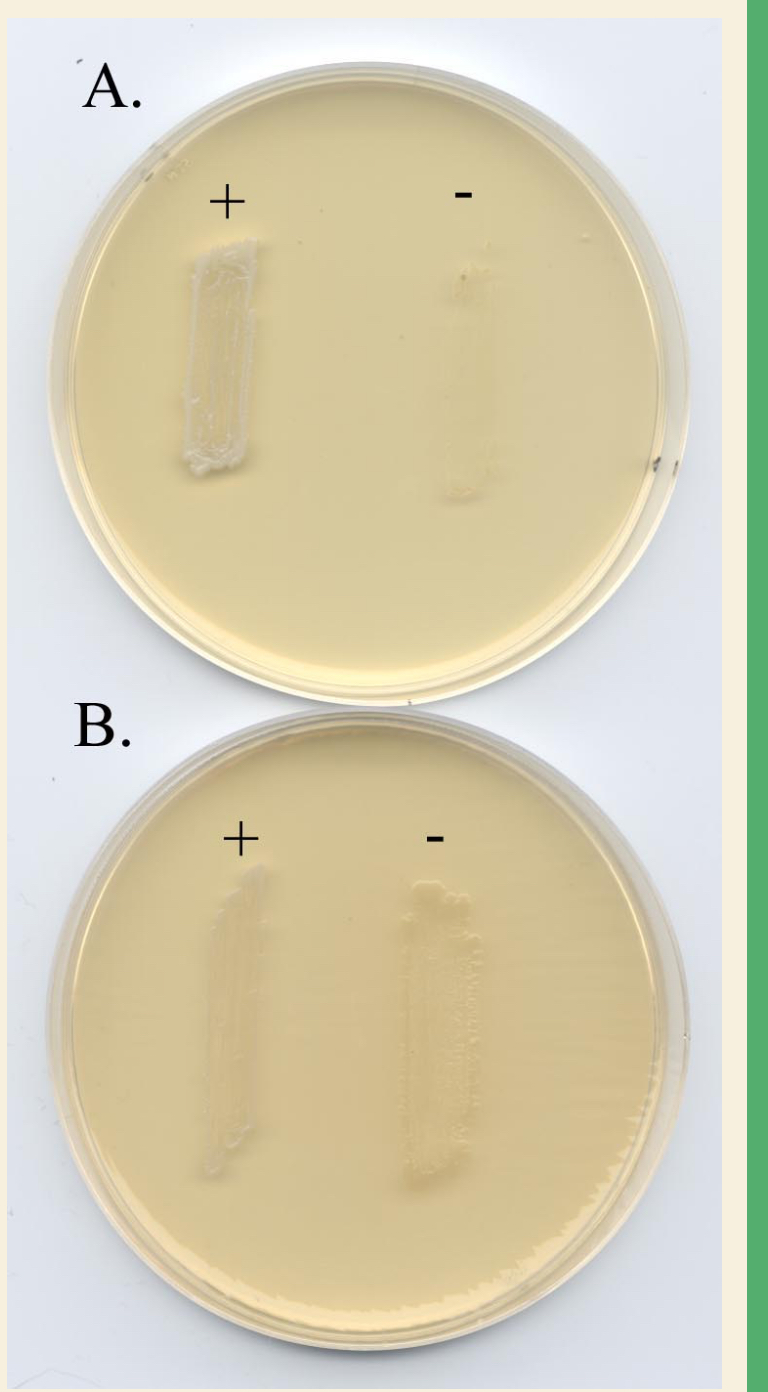
<p>Is B-Phenylethyl Alcohol (PEA) defined or undefined? Is it selective, </p><p>differential, or both? </p>
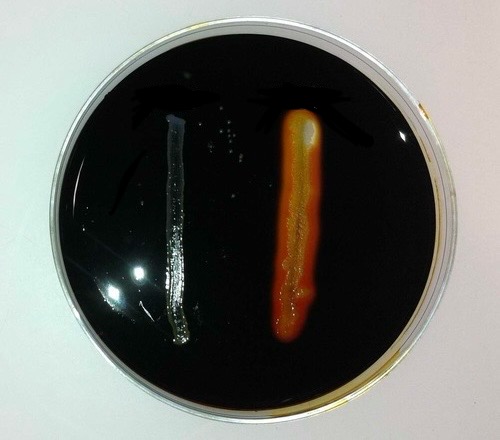
<p>What enzyme are you searching for with starch agar? </p>
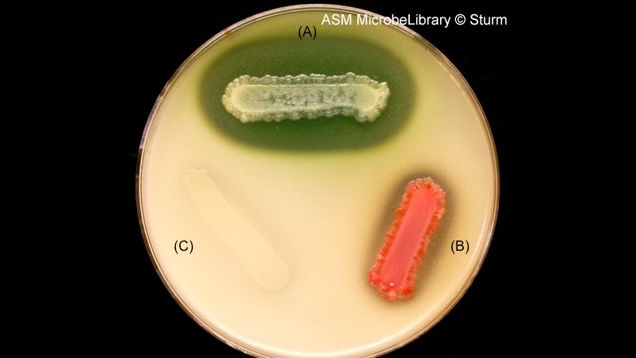
<p>What is broken down in the Casein agar media? What type of macromolecule is it? </p>
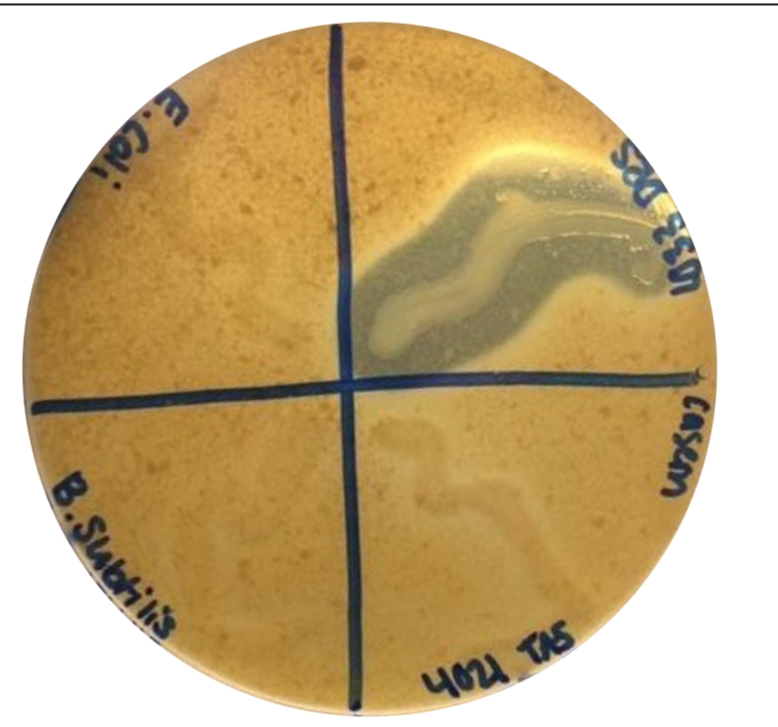
<p>Which organism can hydrolyze casein and produce the exoenzyme casease? </p>
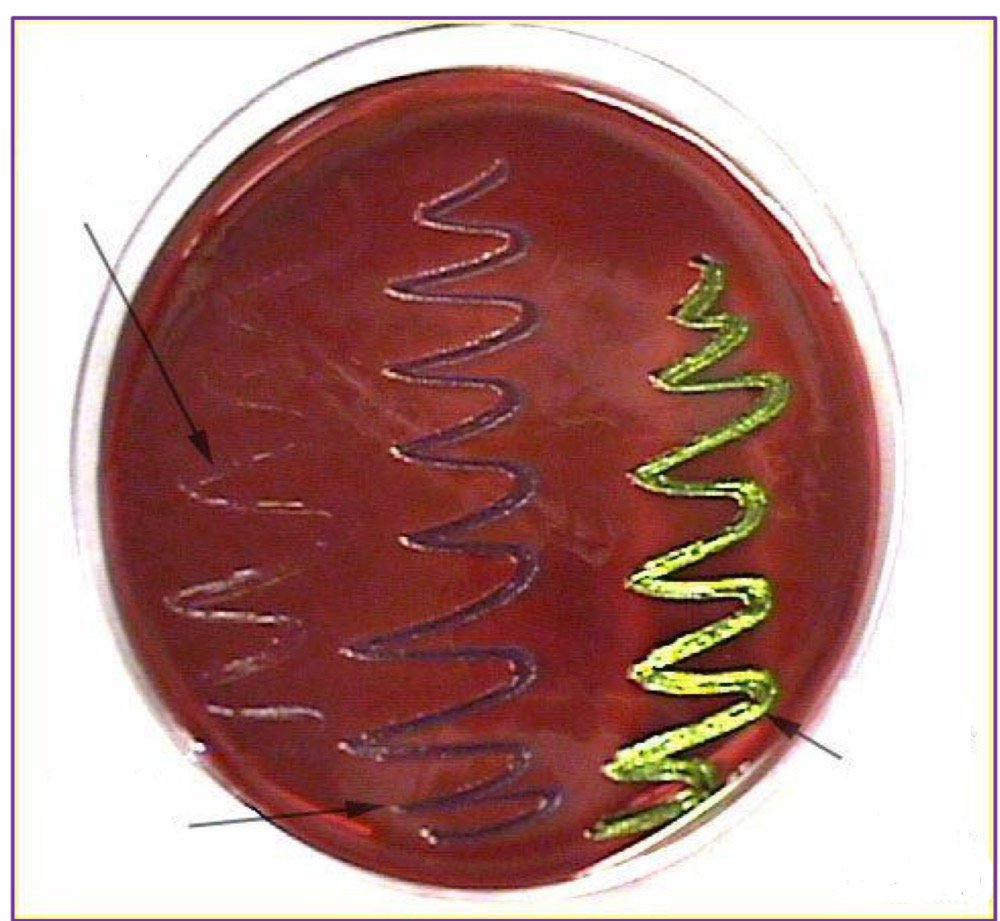
<p>Which streak indicates a positive result and can ferment lactose? </p>

1/75
Looks like no tags are added yet.
Name | Mastery | Learn | Test | Matching | Spaced | Call with Kai |
|---|
No analytics yet
Send a link to your students to track their progress

Is MacConkey agar defined or an undefined agar? Is it selective or differential?
undefined, selective and differential

In the MacConkey agar, what does the pink side indicate?
lactose fermenting colonies

Is Mannitol Salt Agar defined or undefined medium? Differential, selective, or both?
undefined and both
In Mannitol Agar, what does the yellow media indicate?
ferments mannitol with acid production
What is the role of phenol red in MSA (Mannitol Salt Agar)?
a fermentable carbohydrate
What is the role of phenol red in MSA?
is a pH indicator
What type of media is Blood agar?
differential
What type of hemolysis is shown in the blood agar?
beta (complete lysis of red blood cells)
What type of hemolysis is shown in the blood agar?
alpha (partial lysis of red blood cells)

What type of hemolysis is shown in this blood agar?
gamma (no change)

Which tube indicates a positive coagulase test?
top tube

Which tube shows a negative coagulase test?
bottom tube

What type of test is been shown in the image?
An urea test

Which tubes indicates a positive urea test?
pink tube

What is broken down in the urea broth media?
urea

What enzyme is used for this breakdown in urea broths?
urease

What waste product is produced that causes the pH change?
ammonia

What test is being shown in the image?
the indole production test

Which tube indicates positive results for indole production?
tube A

What product are you testing for in the Tryptone media?
indole

What enzyme are you testing for in the tryptophan broth?
tryptophanase
What does this plate show?
Swarming

What media is being shown in the image?
Motility Agar

Which tube indicates a positive result for motility?
left tube

What is the cause of the red color seen in the motility media? (what chemical in the media produces that color)
tetrazolium salt (TTC)

What test is being shown in the image?
Phenol Red

Which tube shows gas production?
far right tube

Examples of carbohydrate sources that can be used in phenol red broths
glucose, lactose, sucrose, mannitol, maltose, arabinose, etc.

Which tube indicates fermentation?
yellow tubes

What is the pH indicator in the phenol red broths?
phenol red

What is label one on the microscope?
ocular lenses

What is label 2 on the microscope?
fine and coarse focusing knobs

What is label 3 on the microscope?
stage controller

What is label 4 on the microscope?
mechanical stage and clips

What is label 5 on the microscope?
objective lenses

What is label 6 on the microscope?
light source

What type of staining was done to this slide?
Endospore staining

What type of staining is shown in the image?
Acid-Fast Staining

What does A indicate?
an acid-fast positive result

What does B indicate?
an acid-fast negative result

How are acid-fast cell structures different from other bacteria cells that are stainable by gram stain?
Acid-fast bacteria have cell walls that contain unusual complex lipids (mycolic acids) at the surface of the cell, giving the cells a waxy property. This makes it difficult for stains to penetrate and stain the cell.
Is B-Phenylethyl Alcohol (PEA) defined or undefined? Is it selective,
differential, or both?
undefined, selective

What is PEA selective against?
gram-negative organisms
Define Mesophile
organisms that grow at temperatures between 20*C - 45*C
Define Psychrophile
organisms that grow at temperatures between 0*C - 5*C
Define Thermophile
organisms that grow at temperatures between 45*C - 90*C

In the thiogylcolate broth, where would you expect to see growth of a strict aerobe?
top of tube

In the thioglycolate broth, where would you expect to see growth of a strict anaerobe?
bottom of tube

In the thioglycolate broth, where would you expect to see growth of a facultative anaerobe?
throughout the tube

What test is being shown in the image?
catalase test

What is the reaction equation of the catalase test?
2H2O2 —> 2H2O + O2

What causes the bubbling?
release of oxygen gas when catalase breaks down hydrogen peroxide

What test is shown in the image?
Starch Hydrolysis Assay

Which side shows a positive starch hydrolysis?
right side
What enzyme are you searching for with starch agar?
a-amylase

What is broken down in the Starch agar media when there is a clearing?
starch (amylase and amylopectin)

What test is shown in the image?
Casein Hydrolysis Assay

What test is being shown in the image?
Casein Hydrolysis Assay

What enzyme are you searching for with milk agar media?
casease
What is broken down in the Casein agar media? What type of macromolecule is it?
casein and a protein
Which organism can hydrolyze casein and produce the exoenzyme casease?
the zone with a clearing
What does the most probable number mean?
a statistical estimate of the number of viable coliform bacteria in a water sample

Is EMB agar defined or an undefined agar? Is it selective, differential, or both?
undefined and both

What is EMB selective for?
gram negative bacteria

What is EMB selective against?
gram positive bacteria
Which streak indicates a positive result and can ferment lactose?
middle streak (purple) and left streak (metallic green sheen)

What test is being shown in the image?
MR-VP Procedure

How do you know if VP is positive?
turns red in 60 minutes

How do you know if MR is positive?
if it turns red immediately

What waste product are you looking for in the methyl red?
mixed acid fermentation

What waste product are you looking for in the VP test?
acetoin

What media is shown in the image?
Citrate slants (citrate utilization procedure)

Which tube indicates a positive result?
tube that turned blue

What is the carbon source in the citrate media?
sodium citrate

What enzyme are we testing for in the citrate utilization?
citrate permease